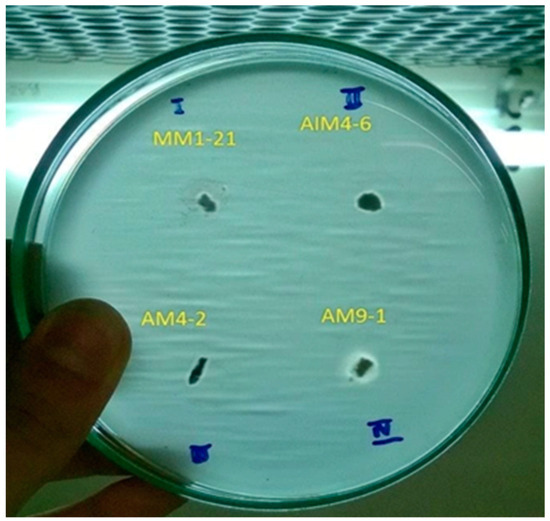
Production of Lipase from Streptomyces spp. AM9-01 by Solid-State

マイストア
変更
お店で受け取る
(送料無料)
配送する
納期目安:
2025.12.21 3:3頃のお届け予定です。
決済方法が、クレジット、代金引換の場合に限ります。その他の決済方法の場合はこちらをご確認ください。
※土・日・祝日の注文の場合や在庫状況によって、商品のお届けにお時間をいただく場合がございます。
Apple Samsung Galaxy A25 5G 64GB ライトブルー① 新品未開封の詳細情報
Samsung Galaxy A25 5G 64GB ライトブルー① 新品未開封。Production of Lipase from Streptomyces spp. AM9-01 by Solid-State。Attachment Paper-3 Lyst8178 | PDF | Matrix (Mathematics) | Ratio。余市のシングルモルトウイスキー3本セット、豊かな風味が特徴。♦ 白州 18年 700ml 箱付 サントリー ウイスキー。- ブランド: 余市- 種類: シングルモルトウイスキー- 数量: 3本セットご覧いただきありがとうございます。専用(ボトルのみ)。
ベストセラーランキングです
近くの売り場の商品
カスタマーレビュー
オススメ度 4.3点
現在、5993件のレビューが投稿されています。